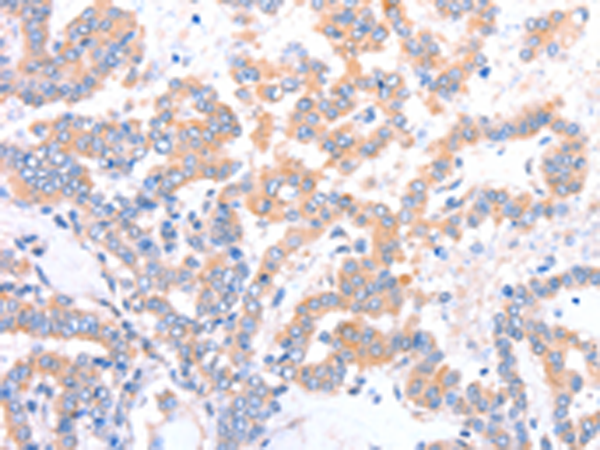
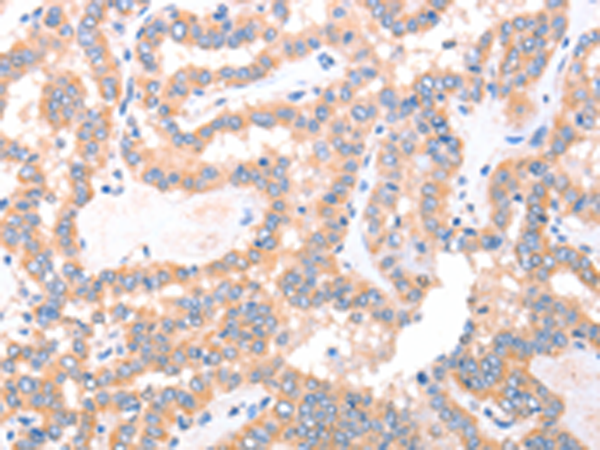
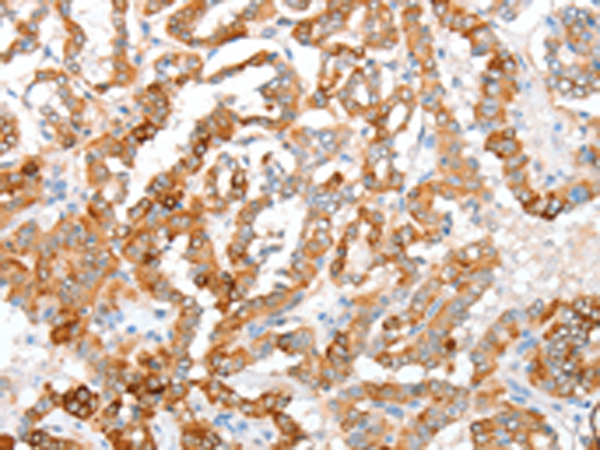

-
分类: 科研抗体货号: P07744别名: ACAD-11应用: WB,IHC反应种属: Human, Mouse, Rat
-
分类: 科研抗体货号: P07743别名: NPD002应用: IHC反应种属: Human, Mouse
-
分类: 科研抗体货号: P07760别名: Tact1应用: IHC反应种属: Human, Mouse, Rat
-
分类: 科研抗体货号: P07742别名: ARC42; ACAD-8应用: IHC反应种属: Human, Mouse
-
分类: 科研抗体货号: P07758别名: ALK7; ACVRLK7应用: IHC反应种属: Human, Mouse, Rat
-
分类: 科研抗体货号: P07741别名:应用: IHC反应种属: Human
-
分类: 科研抗体货号: P07757别名: MCP; AFCP应用: WB,IHC反应种属: Human, Mouse, Rat
-
分类: 科研抗体货号: P07740别名: DSAEC应用: WB,IHC反应种属: Human, Mouse, Rat
-
分类: 科研抗体货号: P07756别名: ACT; dJ393D12.2; RP3-393D12.2应用: IHC反应种属: Human, Mouse, Rat
-
分类: 科研抗体货号: P07766别名: ACY-3; HCBP1应用: WB,IHC反应种属: Human, Mouse

鄂公网安备42018502007531号
鄂公网安备42018502007531号

